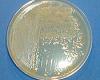

Ebben a képtárban a talajban élő mikroorganizmusok közül a baktériumokat, morfológiájukat, biokémiai tulajdonságaikat és a talajban betöltött szerepét ismertetjük.
Röviden kitérünk az ember szempontjából történő hasznosíthatóságukra és kockázataikra is. A hasznosíthatóság és a károk, kockázatok részletesen az alapismeretek mátrix hasznok és kockázatok celláiban találhatóak meg.
Forrás
A kezdőkép forrása: http://xtekh.aabiotekh.com/nutri_cycle.htm